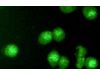

Santa Cruz Biotechnology, Inc.

Santa Cruz Biotechnology, Inc. - p21 Waf1/Cip1/CDKN1A Antibody (F-5)
Anti-p21 Waf1/Cip1/CDKN1A Antibody (F-5) is a mouse monoclonal IgG2b κ p21 Waf1/Cip1/CDKN1A antibody, cited in 1,740 publications, provided at 200 µg/mlMost popular related searches

- Anti-p21 Waf1/Cip1/CDKN1A Antibody (F-5) is a mouse monoclonal IgG2b κ p21 Waf1/Cip1/CDKN1A antibody, cited in 1,740 publications, provided at 200 µg/ml
- raised against amino acids 1-159 representing full length p21 Waf1/Cip1 of mouse origin
- Anti-p21 Waf1/Cip1/CDKN1A Antibody (F-5) is recommended for detection of p21 Waf1/Cip1 of mouse, rat and human origin by WB, IP, IF, IHC(P) and FCM
- Anti-p21 Waf1/Cip1/CDKN1A Antibody (F-5) is available conjugated to agarose for IP; HRP for WB, IHC(P) and ELISA; and to either phycoerythrin or FITC for IF, IHC(P) and FCM
- also available conjugated to Alexa Fluor® 488, Alexa Fluor® 546, Alexa Fluor® 594 or Alexa Fluor® 647 for WB (RGB), IF, IHC(P) and FCM, and for use with RGB fluorescent imaging systems, such as iBright™ FL1000, FluorChem™, Typhoon, Azure and other comparable systems
- also available conjugated to Alexa Fluor® 680 or Alexa Fluor® 790 for WB (NIR), IF and FCM; for use with Near-Infrared (NIR) detection systems, such as LI-COR®Odyssey®, iBright™ FL1000, FluorChem™, Typhoon, Azure and other comparable systems
- also available conjugated to biotin for WB, IHC(P) and ELISA; and to either TRITC or Alexa Fluor® 405 for IF, IHC(P) and FCM
- Contact our Technical Service Department (or your local Distributor) for more information on how to receive a FREE 10 µg sample of p21 Waf1/Cip1/CDKN1A (F-5): sc-6246.
- m-IgG Fc BP-HRP and m-IgG2b BP-HRP are the preferred secondary detection reagents for p21 Waf1/Cip1/CDKN1A Antibody (F-5) for WB and IHC(P) applications. These reagents are now offered in bundles with p21 Waf1/Cip1/CDKN1A Antibody (F-5)